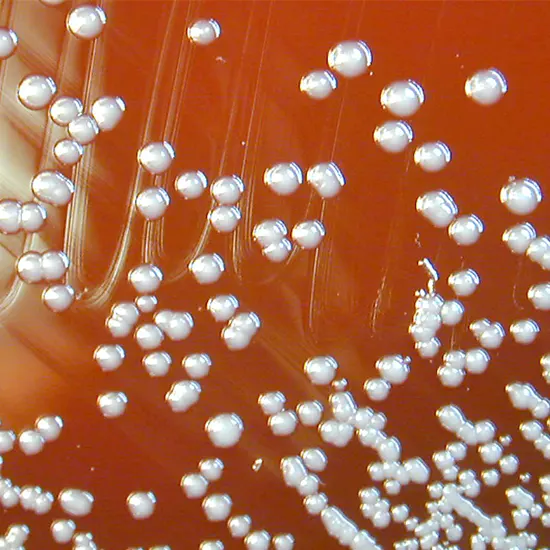
Burkholderia Infection

Book Burkholderia Infection Appointment Online Near me at the best price in Delhi/NCR from Ganesh Diagnostic. NABL & NABH Accredited Diagnostic centre and Pathology lab in Delhi offering a wide range of Radiology & Pathology tests. Get Free Ambulance & Free Home Sample collection. 24X7 Hour Open. Call Now at 011-47-444-444 to Book your Burkholderia Infection at 50% Discount.
Burkholderia infection refers to an infection caused by bacteria belonging to the genus Burkholderia. Burkholderia is a large genus of Gram-negative, aerobic bacteria that are found in diverse environments, including soil, water, plants, and animals. Some species within the Burkholderia genus can cause infections in humans, including respiratory tract infections, bloodstream infections, skin and soft tissue infections, and other systemic infections.
Diagnosis of Burkholderia infections typically involves clinical evaluation, history of exposure to risk factors, and laboratory testing, such as bacterial culture and identification of the specific Burkholderia species involved. Antibiotic susceptibility testing is also important to guide appropriate treatment.
|
Blood Culture and Sensitivity |
|
250 |
|
Urine Culture |
|
375 |
|
Sputum Culture and Sensitivity |
|
200 |
|
X-Ray Chest |
|
225 |
|
CT Chest |
|
2500 |
|
Total Price |
|
2500 |
| Test Type | Burkholderia Infection |
| Includes | Burkholderia Infection (Common Diseases) |
| Preparation | |
| Reporting | Within 24 hours* |
| Test Price |
₹ 3550
|

Early check ups are always better than delayed ones. Safety, precaution & care is depicted from the several health checkups. Here, we present simple & comprehensive health packages for any kind of testing to ensure the early prescribed treatment to safeguard your health.